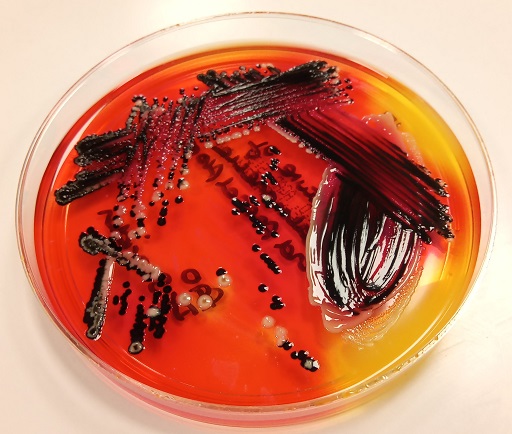
Described image

4.3.3 Enteric pathogens
Your laboratory will almost certainly identify a wide variety of enteric pathogens from stool samples. For GLASS, the focus is on Salmonella and Shigella.
The first step in identification is the appearance of colonies on solid media. For example, on
-
Why is it important to do a urease test?
-
NLF enteric organisms, such as Proteus and related species (Providentia, Serratia and Morganella) have a similar appearance on solid media. It is therefore important to do a urease test to prevent mis-identifying these as enteric pathogens.
Confirmatory tests for Salmonella and Shigella include:
- a negative oxidase test – to differentiate from other NLF organisms like Pseudomonas
- Kligler’s Iron Agar (
KIA ) test - biochemical tests
- antisera agglutination tests
For details of all tests, see the UK
SMI guidance for Salmonella (PHE, 2021) and Shigella (PHE, 2022)
4.3.2 Haemophilus influenzae